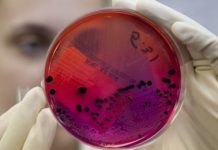
Шестеро детей в возрасте от одного года до 13 лет госпитализированы в Узынсу Шестеро детей в возрасте от одного года до 13 лет госпитализированы в Узынсу
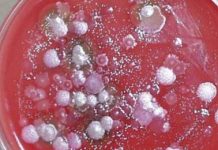
Главный ветеринарный-санитарный врач области: В Прииртышье сибирская язва не выявлена Главный ветеринарный-санитарный врач области: В Прииртышье сибирская язва не выявлена

В Иртышском районе сибирской язвы нет – главный ветеринарный санитарный инспектор Павлодарской области
"В Иртышском районе сибирской язвы нет", – заявил на специальном брифинге главный государственный ветеринарный санитарный инспектор Павлодарской области Рашид Нурбеков. Результаты проведенных исследований показали:...
В Павлодарской области заподозрили сибирскую язву у двух жителей села
Двух жителей села Узынсу Иртышского района Павлодарской области госпитализировали в инфекционную больницу с подозрением на сибирскую язву, передает Bnews.kz. По информации областного управления...
Шестеро детей в возрасте от одного года до 13 лет госпитализированы в Узынсу
Число контактировавших с потенциально зараженным сибирской язвой животным возросло до 25 человек, сообщает корреспондент Today.kz со ссылкой на руководителя управления здравоохранения Нурлана Касимова. ...
В Алматы неоднократно судимый мужчина совершил убийство 6-летней девочки
В Алматы неоднократно судимый мужчина совершил убийство 6-летней девочки. Об этом сообщила официальный представитель ДВД города Салтанат Азирбек, передает Казинформ. По ее данным,...
«Тараз» минимально переиграл «Иртыш»
Источник: zakon.kz
Главный ветеринарный-санитарный врач области: В Прииртышье сибирская язва не выявлена
Анализы двух жителей Павлодарской области с подозрением на сибирскую язву показали - диагноз болезни не подтвердился, передает BNews.kz. Об этом заявил Главный государственный...
Поезд Актобе-Актау шесть часов простоял в степи по вине ремонтиков
"Поезд Актау-Актобе 8 июля стоял в степи 6 часов. В вагонах жара. Все люди с детьми. И 6 часов сидели на рельсах рядом с...
Сибирская язва в Павлодарской области: два человека госпитализированы, ещё 25 под наблюдением медиков
Руководитель управления здравоохранения Павлодарской области Нурлан Касимов подтвердил информацию о госпитализации двух жителей Иртышского района. 8 июля сельчан перевезли санитарной авиацией в областную инфекционную...
В ОБСЕ поздравили Казахстан с избранием в состав Совета Безопасности ООН
В Организации по безопасности и сотрудничеству в Европе поздравили Казахстан с избранием в состав непостоянных членов Совета Безопасности Организации Объединенных Наций, передает News2.kz со ссылкой на...
Назначен аким Иргизского района Актюбинской области
В Иргизском районе Актюбинской области назначили нового акима, передает Казинформ. Как сообщили в акимате региона, распоряжением акима Актюбинской области Бердыбека Сапарбаева в соответствии...